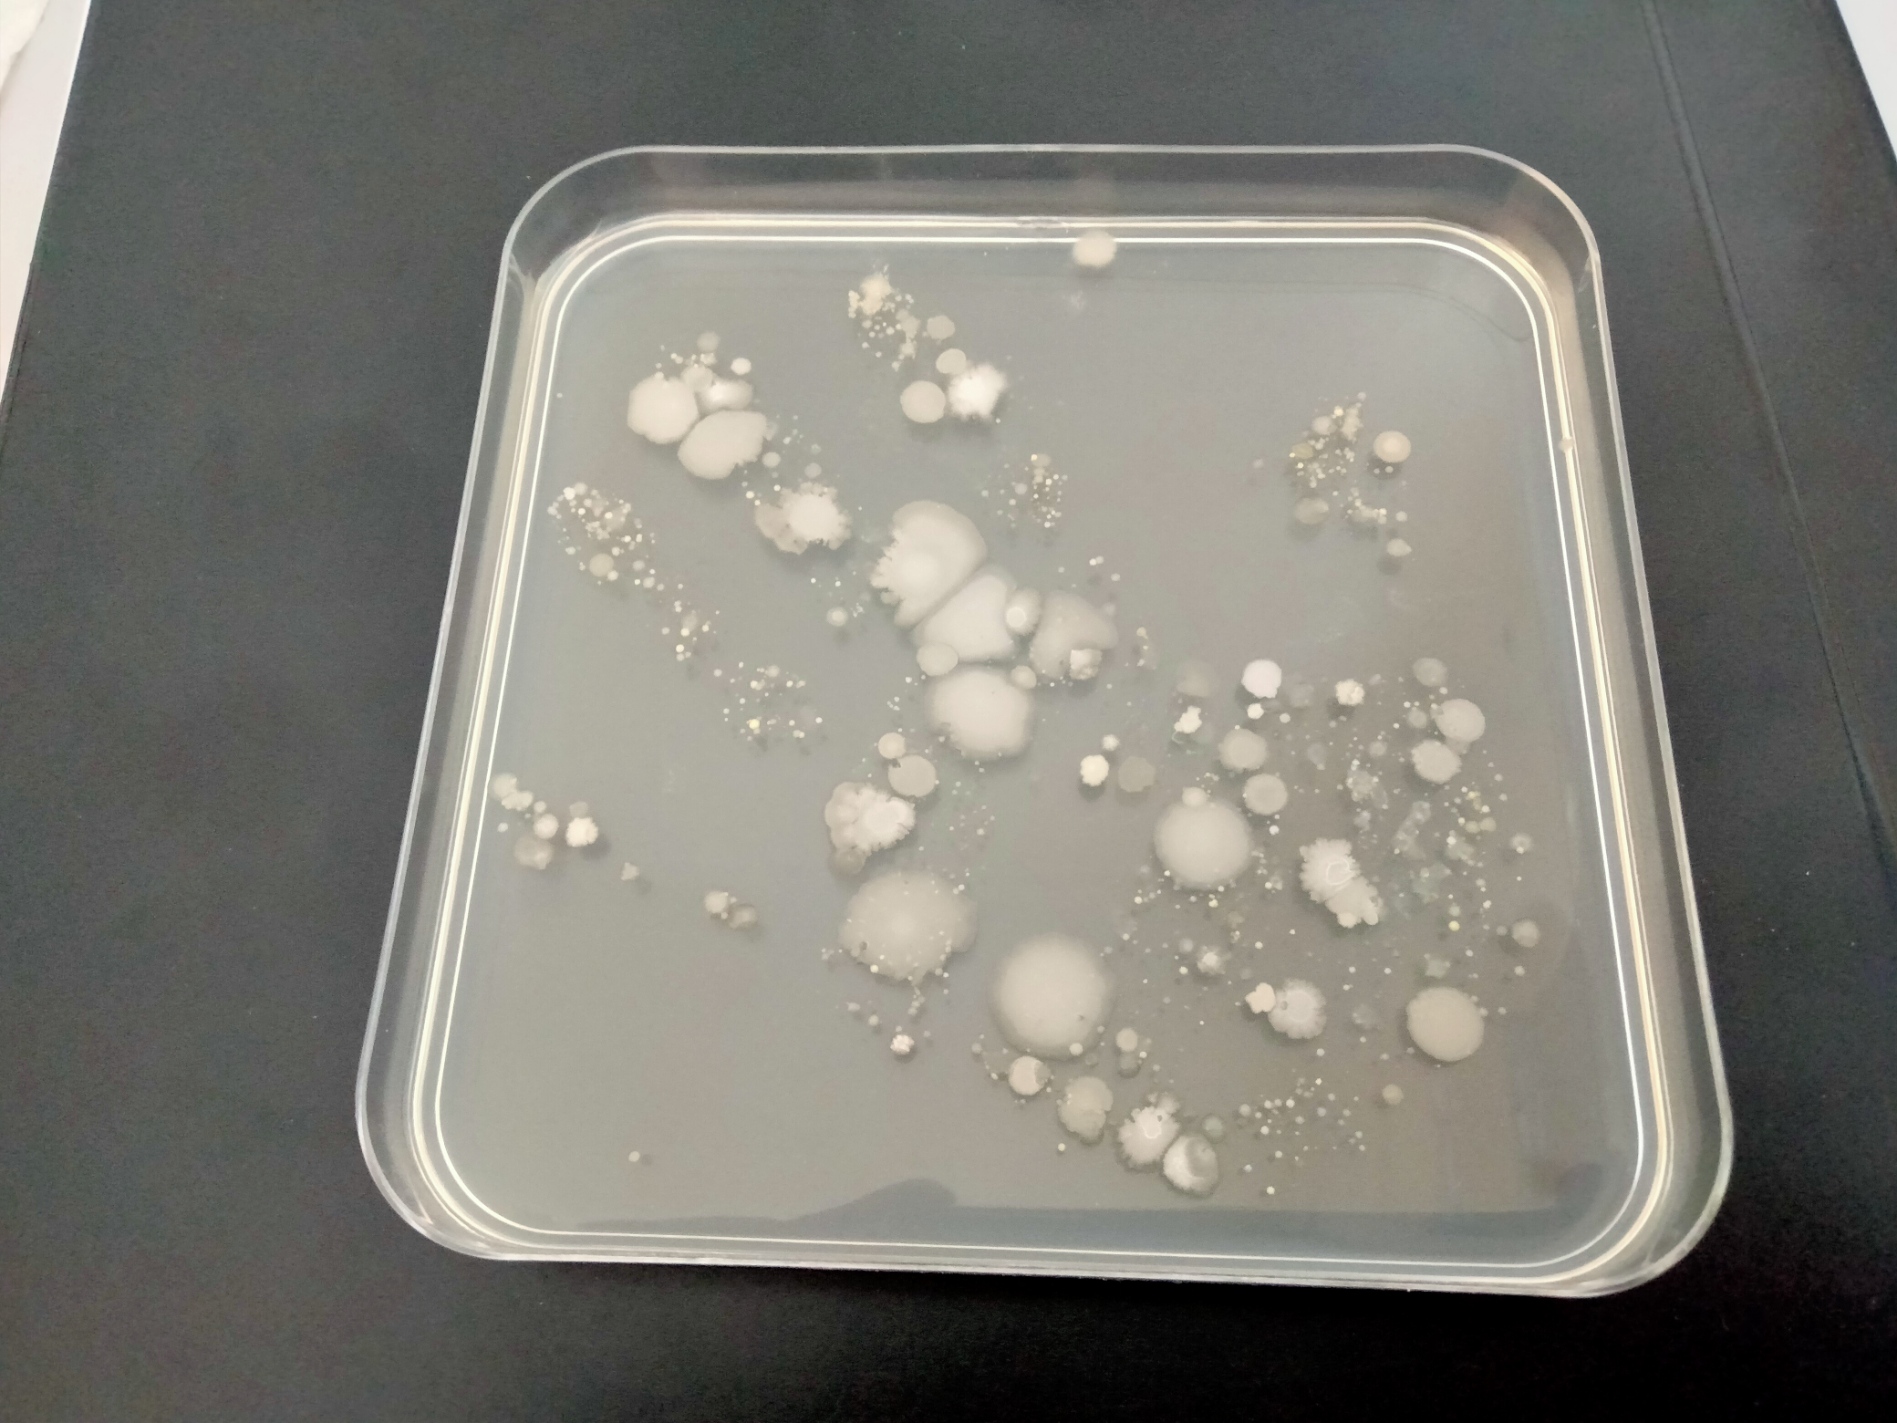

Detetive de micróbios
Descrição da atividade
Esta atividade surge no âmbito de uma parceria com o SalivaTec, laboratório do Centro de Investigação Interdisciplinar em Saúde, da Universidade Católica Portuguesa em Viseu. Os alunos realizam atividades práticas em grupo, manipulando alguns materiais como tintas, sabão, placas de Petri, entre outros, para compreenderem o efeito de alguns comportamentos no desenvolvimento de microrganismos. Desafiam-se os alunos a conceber materiais de divulgação sobre a temática, para partilhar com os encarregados de educação e divulgar no ambiente escolar e nas redes sociais. Por último, os alunos resolvem problemas de matemática relacionados com o desperdício resultante da atividade prática.
Tinta para colocar nas mãos (vermelha, amarela, azul)
3 placas de Petri com meio de cultura por grupo
Batas
Marcador permanente para escrever nas placas de Petri
Fita cola
Água
Álcool Gel desinfetante
Cronómetro
Documento de escrita colaborativa, Google Sheets
Folha de cálculo colaborativa para registo dos resultados a obter na atividade II.
Perfil dos alunos
Aprendizagens essenciais
Please download the following files:
Guiões de atividade
Introdução da atividade
Inicia-se a atividade com uma apresentação eletrónica sobre microrganismos, formulando-se questões como:
- O que são micróbios ou microrganismos?
- É possível observar micróbios a olho nu?
- Onde podemos encontrar micróbios?
- Existem micróbios “bons”? E maus?
Desenvolvimento da atividade
Informam-se os alunos sobre a realização de duas atividades práticas e projeta-se o protocolo seguinte, explorando cada um dos passos:
Atividade 1 – “Mãos limpas”
1. Organiza-se a turma em 5 grupos. Cada elemento do grupo irá desempenhar uma função distinta:
- Aluno(s) - Cobrir as mãos com tinta
- Aluno(s) - Contar o tempo
- Aluno(s) - Registar os resultados
2. Distribui-se uma bata por cada aluno e apresenta-se cada uma das seguintes condições experimentais descritas na Tabela A:
3. Distribuem-se três folhas de papel A4, por grupo, devidamente identificadas e com os intervalos de tempo correspondentes a cada experiência (ver exemplo seguinte - Tabela B).
4. Um aluno cobre as mãos com tinta com a ajuda de um colega e, de seguida, “imprime” as mãos no respetivo campo da folha de registo (0 segundos).
5. O aluno volta a cobrir as mãos com tinta e lava as mãos apenas com água durante 5 segundos (o colega responsável por contar o tempo utiliza o cronómetro para o efeito).
6. Após lavar as mãos, o aluno seca as mãos numa toalha/papel absorvente, sem as esfregar.
7. Seguidamente, com ajuda dos colegas de grupo “imprime” as mãos no respetivo campo da folha de registo (5 segundos).
8. O aluno volta a cobrir as mãos com tinta e lava as mãos apenas com água durante 20 segundos (o colega responsável por contar o tempo utiliza o cronómetro para o efeito).
9. Os alunos repetem os passos 6 e 7 (imprimindo as mãos no respetivo campo da folha de registo - 20 segundos).
Recolhem-se os registos dos resultados de cada grupo, devidamente identificados, e expõem-se na sala de aula para que todos os alunos possam observar os resultados e estabelecer comparações. Orienta-se a discussão a partir das respostas dos alunos, formulando-se questões como:
- Em qual das três experiências que realizaram a impressão da mão é mais visível? Porquê?
- Todos os grupos obtiveram o mesmo resultado? Algum grupo obteve um resultado diferente?
- Em caso afirmativo, discutem-se possíveis razões para o sucedido.
- Qual(ais) a(s) conclusão(ões) possível(eis) que podemos apresentar para os resultados obtidos?
Em seguida, projeta-se o segundo protocolo, analisando cada etapa com os alunos.
Atividade 2 – “Os meus dedos têm vida”
1.Limpa-se a bancada de trabalho com álcool. Como os microrganismos estão em todo o lado, até mesmo na bancada de trabalho, facilmente podem contaminar as placas de Petri que serão utilizadas na atividade. Assim, para que na placa de Petri cresçam apenas os microrganismos provenientes das mãos, é necessário desinfetar a bancada com álcool, antes do início da atividade.
2. Distribuem-se 3 placas de Petri com meio de cultura (TSA, Tryptic Soy Agar ou NA, Nutrient Agar) por cada grupo. O professor ou os alunos devem identificar a placa com o nome do grupo, usando para isso um marcador permanente (identificar na parte da placa que contém o meio de cultura e não na tampa, pois é possível que em algum momento se confundam/ troquem as tampas).
3. Um aluno de cada grupo passa suavemente os dedos pelo meio de cultura da primeira placa de Petri, deixando as suas ‘impressões digitais’. Em seguida, fecha a placa com a respetiva tampa.
Nota: Deve evitar-se perfurar o meio de cultura. Os alunos vão estranhar o facto de não observarem no imediato uma alteração no meio, tendendo a imprimir com maior força os dedos, o que pode danificar a superfície do meio. Devem ser informados de que é suficiente tocar com os dedos para o sucesso da experiência, algo que irão descobrir mais tarde.
4. O mesmo aluno de cada grupo lava as mãos apenas com água e repete o procedimento 3, na segunda placa de Petri.
5. O mesmo aluno de cada grupo lava as mãos com gel desinfetante e repete o procedimento 3, na terceira placa de Petri.
6. Recolhem-se todas as placas e selam-se com fita-cola ou película aderente.
7. Colocam-se as 3 placas de cada grupo numa incubadora entre 30 ⁰C e 37 ⁰C, durante 24 h a 48 h. Se a escola não possuir este equipamento, colocam-se as placas num ambiente quente (sem exposição direta à luz do sol).
8. Retiram-se as placas da incubadora (ou do ambiente quente) e distribuem-se pelos respetivos grupos de alunos.
9. Observam-se as colónias que se desenvolveram nas placas (sem abrir).
Nota: Se não for possível observar os resultados após este período, as placas devem ser guardadas dentro de um saco de plástico (fechado), no frigorífico (para evitar condensação na tampa, devem guardar-se as placas com a tampa virada para baixo). Deste modo, promove-se uma melhor visualização dos resultados: no frigorífico o crescimento dos microrganismos abranda, impedindo que a placa fique com muitas colónias sobrepostas ou que, sem espaço para se multiplicarem, os microrganismos comecem a morrer.
Após o surgimento dos resultados (formação de colónias – ou não – nas placas de Petri), pega-se em três placas de um grupo cujas diferenças de resultados sejam muito claros e formulam-se questões como:
- Que manchas serão estas que se formaram na placa (apontando para aquela em que o aluno tocou sem lavar as mãos)?
- Por que razão nesta placa (apontando para aquela em que o aluno tocou depois de passar as mãos com gel desinfetante) não se desenvolveram microrganismos?
- Qual é a conclusão que é possível tirar depois de observarmos os resultados desta atividade prática?
Finaliza-se esta parte projetando um folheto da DGS relacionada com Normas Gerais sobre Lavagem de Mão a propósito do Corona vírus COVID-19 ou um vídeo sobre o tema.
Solicita-se aos alunos que, em grupo, respondam aos desafios da parte II do guião do aluno. Quanto à questão 1, ao circular pelos grupos, questiona-se os alunos sobre os raciocínios/ estratégias usadas para a resolução da questão.
No que toca à questão 2, auxiliar os alunos a contar as colónias, ajudando a diferenciar as mesmas.
Na construção de uma tabela solicitada na questão 2.1 (Guião do aluno, Parte II), questionam-se os alunos sobre quais os dados que podem ser organizados numa tabela. Sugere-se que explorem diferentes formas de construção da tabela:

Para responder à questão 2.2 (Guião do aluno, Parte II), pede-se aos alunos que abram o ficheiro “Colónias nas placas de Petri” disponibilizado no ambiente de trabalho dos computadores de cada grupo para que preencham os respetivos dados numa mesma folha de cálculo de escrita colaborativa.
A partir do gráfico resultante dos dados colocados na folha de cálculo, questiona-se os alunos sobre a relação entre as condições experimentais nas várias caixas e o número de colónias observado.
Conclusão da atividade
Solicita-se aos alunos que, em grupo, elaborem um panfleto informativo para partilhar com os encarregados de educação. Um dos grupos pode ser incumbido de criar um poster para afixar na escola. O panfleto/poster pode conter respostas à seguintes questões:
- O que são microrganismos?
- Onde os podemos encontrar?
- São visíveis a olho nu?
- Como são transmitidos?
Os alunos pesquisam imagens para integrar nos seus trabalhos. Estes podem ser concebidos com ferramentas digitais, tais como:
- Canva
- PowerPoint
- Google Slides
- Outros
Aprendizagens essenciais
Evidence / Student action
- Identificar situações e comportamentos de risco para a saúde e a segurança individual e coletiva, propondo medidas de prevenção e proteção adequadas
- Informação a constar no panfleto informativo que deverá ser enviado para os EE.
- Saber colocar questões, levantar hipóteses, fazer inferências, comprovar resultados e saber comunicar, reconhecendo como se constrói o conhecimento.
- Participação oral durante a formulação de questões pelo docente, por exemplo, no final da realização das atividades práticas
- Questões estatísticas, recolha e organização de dados - Recolha de dados (fontes primárias e métodos): Participar na definição de quais os dados a recolher num dado estudo e decidir sobre a fonte primária de dados. Representações gráficas: Representar através de gráficos de barras os dados recolhidos, incluindo fonte, título e legenda. Análise crítica de gráficos: Decidir sobre qual(is) as representações gráficas a adotar num dado estudo e justificar a(s) escolha(s).
- Respostas dos alunos à questão 2 (e respetivas alíneas) do Guião do Aluno
- Análise de dados: Interpretação e conclusão - Ler, interpretar e discutir a distribuição dos dados, relacionando tabelas, representações gráficas e a moda, salientando criticamente os aspetos mais relevantes, ouvindo os outros e discutindo de forma fundamentada.
- Discussão em grande grupo das respostas dos alunos à questão 2.3 do Guião do Aluno.
- Comunicação e divulgação de um estudo: Público-alvo - Decidir a quem divulgar um estudo realizado.
- Informação a constar no panfleto informativo que deverá ser enviado para os EE.
Direção-Geral da Saúde. (2020). Novo coronavirus COVID-19: Lavagem das mãos. Acedido em https://www.dgeste.mec.pt/wp-content/uploads/2020/05/DGS_LavagemDasMaos.pdf em 30 de junho de 2022
Instituto Gulbenkian de Ciências. (s.d.). Aqui há Ciência! Mãos limpas, corpo saudável. Acedido em https://educacao.oeiras.pt/atividades_projetos/aquihaciencia/experiencias/Documents/1%20 Maos_limpas_corpo_saudavel_atualizado.pdf em 30 de junho de 2022
Parte 1

Parte II
Já finalizaste a atividade denominada “Os meus dedos têm vida”? Nessa atividade estiveste a investigar qual é a importância da lavagem das mãos para a remoção de microrganismos! Agora, vais analisar alguns números interessantes que resultam dessa atividade.
1. Estima a quantidade de caixas de Petri usadas na atividade prática por todas as turmas do 2.º ano. Apresenta os cálculos que efetuares para apresentar o resultado.
2. Consegues contar o número de colónias formadas nas placas de Petri usadas na experiência I, II e III? Em caso de dúvida, pede ajuda ao teu professor para identificar o número total de colónias, por condição experimental.
2.1 Organiza numa tabela os dados obtidos na questão anterior.
2.2 Abre o documento “Colónias nas placas de Petri” disponível no ambiente de trabalho do teu computador e regista os resultados (número de colónias) obtidos.
2.3 O que podes concluir acerca do gráfico resultante dos dados da tabela preenchida no documento “Colónias nas placas de Petri”? Justifica a tua resposta